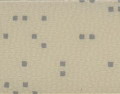
Tarkett得嘉TX163/TX164

Tarkett得嘉TX163/TX164-商務會議室地板
產品說明

|
型號:得嘉 Tarkett TX163/TX164 [TX164] 34級; 適合極高流量商業地方使用。
尺度: [TX163/TX164] 卷 裝- 23m(長)×2m(寬) |
 |

Uni系列(卷材)
|
164:3637001 |
164:3637002 |
164:3637003 |
164:3637004 |
164:3637005 |
|
164:3637006 |
164:3637007 |
164:3637008 |
164:3637009 |
164:3637110 |
|
164:3637011 |
164:3637012 |
164:3637013 |
164:3637014 |
164:3637015 |
|
164:3637016 |
164:3637017 |
164:3637018 |
|
Matrix系列(卷材)
|
163:3633022/164:3634022 |
163:3633023/164:3634023 |
163:3633024/164:3634024 |
163:3633025/164:3634025 |
163:3633026/164:3634026 |
|
163:3633027/164:3634027 |
163:3633028/164:3634028 |
163:3633029/164:3634029 |
163:3633030/164:3634030 |
163:3633031/164:3634031 |
|
163:3633032/164:3634032 |
163:3633033/164:3634033 |
163:3633034/164:3634034 |
163:3633035/164:3634035 |
163:3635001/164:3636001 |
|
|
|
|
|
Sala系列(卷材/塊材)
卷163:3633012/164:3634012 卷163:3633013/164:3634013 塊163:3666013/164:3667013 卷163:3633014/164:3634014 塊163:3666014/164:3667014 卷163:3633015/164:3634015 塊163:3666015/164:3667015 卷163:3633016/164:3634016 卷163:3633017/164:3634017 塊163:3666017/164:3667017 卷163:3633018/164:3634018 塊163:3666018/164:3667018 卷163:3633019/164:3634019 塊163:3666019/164:3667019 卷163:3633020/164:3634020 塊163:3666020/164:3667020 卷163:3633021/164:3634021 塊163:3666021/164:3667021










Dolomite系列 (卷材/塊材)
卷163:3633001/164:3634001 塊163:3666001/164:3667001 卷163:3633002/164:3634002 塊163:3666002/164:3667002 卷163:3633003/164:3634003 塊163:3666003/164:3667003 卷163:3633004/164:363404 塊163:3666004/164:3667004 卷163:3633005/164:3634005 卷163:3633006/164:3634006 卷163:3633007/164:3634007 塊163:3666007/164:3667007 卷163:3633008/164:3634008 卷163:3633009/164:3634009 塊163:3666009/164:3667009 卷163:3633010/164:3634010 塊163:3666010/164:3667010 卷163:3633011/164:3634011 塊163:3666011/164:3667011











Esquisse系列(卷材/塊材)
|
卷163:3631001/164:3632001
|
卷163:3631002/164:3632002
|
卷163:3631003/164:3632003 塊163:3664003/164:3665003 |
卷163:3631004/164:3632004 塊163:3664004/164:3665004 |
卷163:3631005/164:3632005
|
|
卷163:3631006/164:3632006
|
卷163:3631007/164:3632007
|
卷163:3631008/164:3632008 塊163:3664008/164:3665008 |
卷163:3631009/164:3632009 塊163:3664009/164:3665009 |
卷163:3631010/164:3632010 塊163:3664010/164:3665010 |
|
卷163:3631011/164:3632011 塊163:3664011/164:3665011 |
卷163:3631012/164:3632012
|
卷163:3631013/164:3632013 塊163:3664013/164:3665013 |
卷163:3631014/164:3632014 塊163:3664014/164:3665014 |
卷163:3631015/164:3632015
|
Wood系列 (卷材)
|
163:3629001 164:3630001 |
163:3629002 164:3630002 |
163:3629003 164:3630003 |
163:3629004 164:3630004 |
163:3629005 164:3630005 |